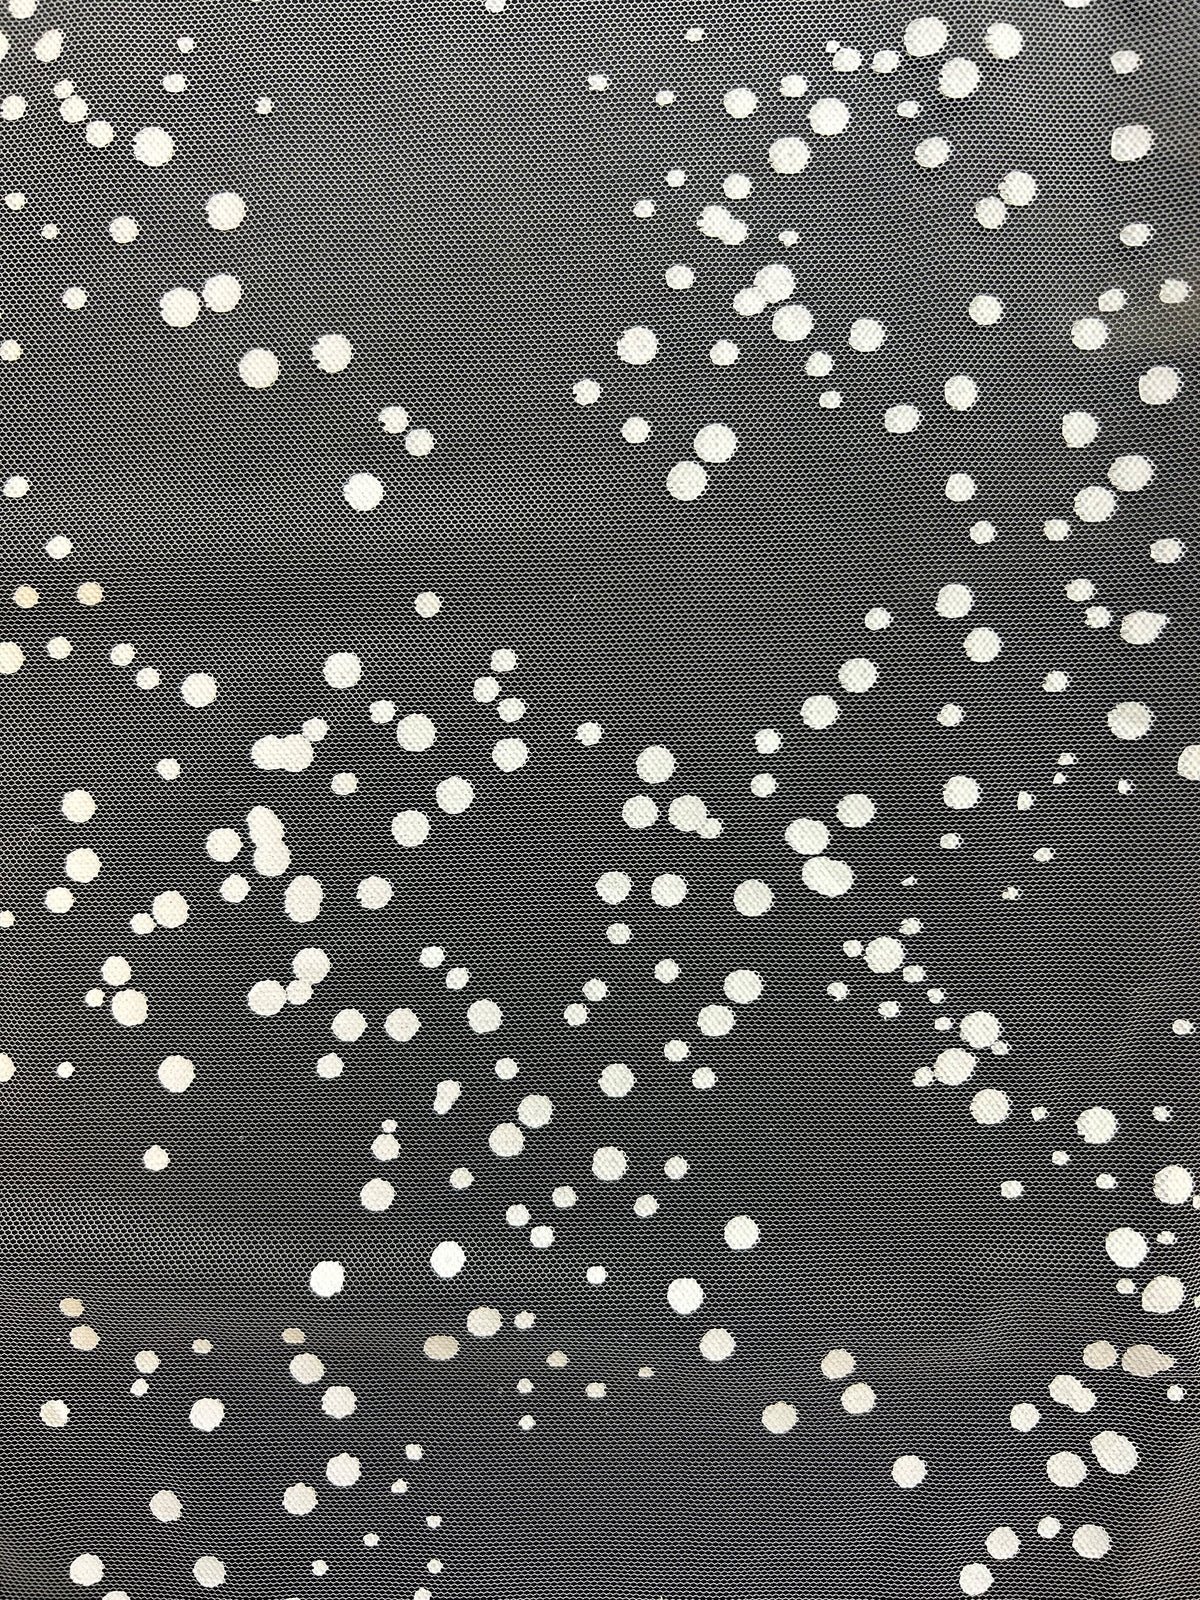

Ergebnisse für "riaz"
Kostenloser Versand im Vereinigten Königreich
Bei allen Bestellungen über 250 £
Kundendienst
+44(0)1254 700 117 von Montag bis Freitag von 9:00 bis 17:00 Uhr
Sichere Bezahlung
Ihre Zahlungsinformationen werden sicher verarbeitet
Kontaktiere uns
Möchten Sie uns kontaktieren? E-Mail: info@bridalfabrics.com